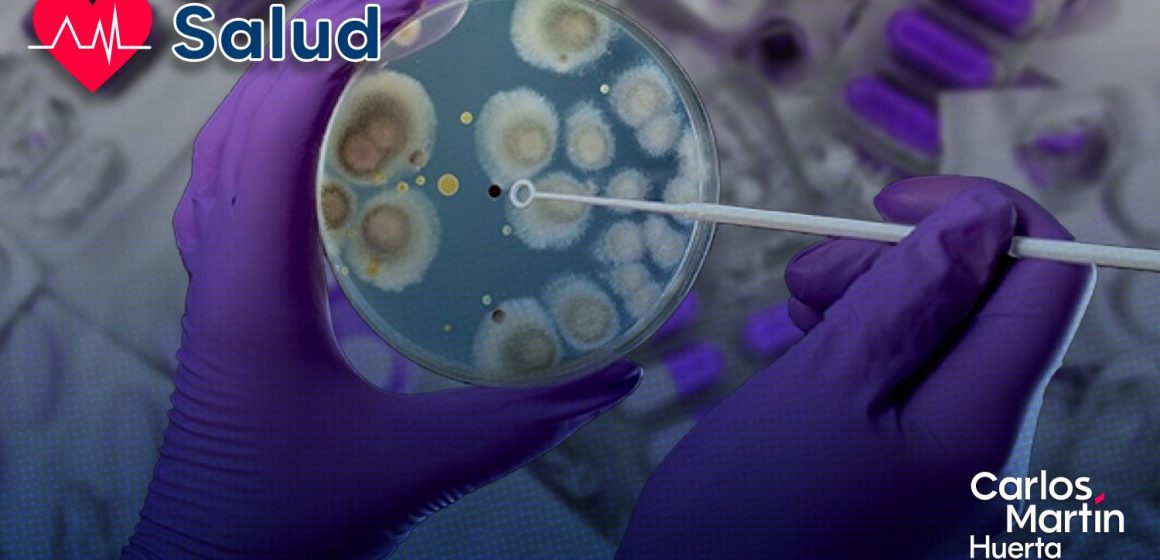
UNAM advierte que en 2050 la resistencia a antibióticos podría causar 10 millones de muertes al año

Thalía Becerra
La resistencia a los antibióticos podría causar la muerte de 10 millones de personas al año a partir de 2050.
Esta alarmante proyección fue compartida por el Dr. Samuel Ponce de León Rosales, coordinador del Programa Universitario de Investigación sobre Riesgos Epidemiológicos y Emergentes de la UNAM.
El problema radica en el abuso y consumo indiscriminado de estos medicamentos, lo que ha generado una inmunidad antimicrobiana que representa un grave riesgo para la salud pública y la práctica médica a nivel global.
Los antibióticos, descubiertos por Alexander Fleming en 1928, han sido cruciales para prevenir y curar infecciones. Sin embargo, su uso incorrecto ha potenciado la capacidad de las bacterias para desarrollar mecanismos de defensa.

¿Cómo se genera la resistencia?
La investigadora Carol Hernández Rodríguez, del Programa Universitario de Bioética, explicó que la resistencia es un resultado natural de la interacción bacteriana que se acelera por diversos factores.
El uso industrial de los antibióticos, su permanencia en el ambiente, su expansión geográfica y la aplicación clínica intensiva son algunos de los elementos que contribuyen al problema.
En este sentido, las bacterias pueden producir enzimas que destruyen el medicamento, modificar los sitios a los que se adhieren los antibióticos, o incluso expulsar activamente el fármaco de su interior.
Estas adaptaciones hacen inútiles a los medicamentos, provocando que las infecciones sean mucho más difíciles, o incluso imposibles, de tratar.

Consecuencias de la resistencia a los antibióticos
La advertencia de la UNAM subraya que los antibióticos son un recurso no renovable. Su ineficacia futura tendría consecuencias catastróficas.
Procedimientos médicos comunes, como cirugías y trasplantes de órganos, se volverían de alto riesgo. Una simple herida podría convertirse en una amenaza mortal si se infecta con una bacteria resistente.
Además, los costos de los tratamientos se dispararían y muchas enfermedades crónicas, como la diabetes y la insuficiencia renal, verían un incremento en su tasa de mortalidad debido a infecciones secundarias.
Para contrarrestar esta tendencia, los expertos de la UNAM recomiendan implementar estrategias para disminuir el uso excesivo de estos fármacos desde el ámbito personal y público.
Te puede interesar: Explosión en Iztapalapa: Aumentan a 30 las víctimas mortales